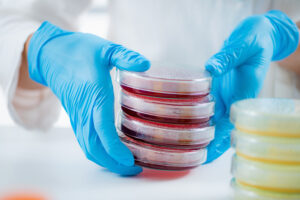
Condensation in petri dishes during routine laboratory incubation

Why Your PCR Results Vary: The Overlooked Impact of PCR Plate Design
Introduction In many PCR and qPCR workflows, inconsistent results are often traced back to familiar explanations—reagent quality, pipetting variation, or thermal cycler performance—the usual suspects